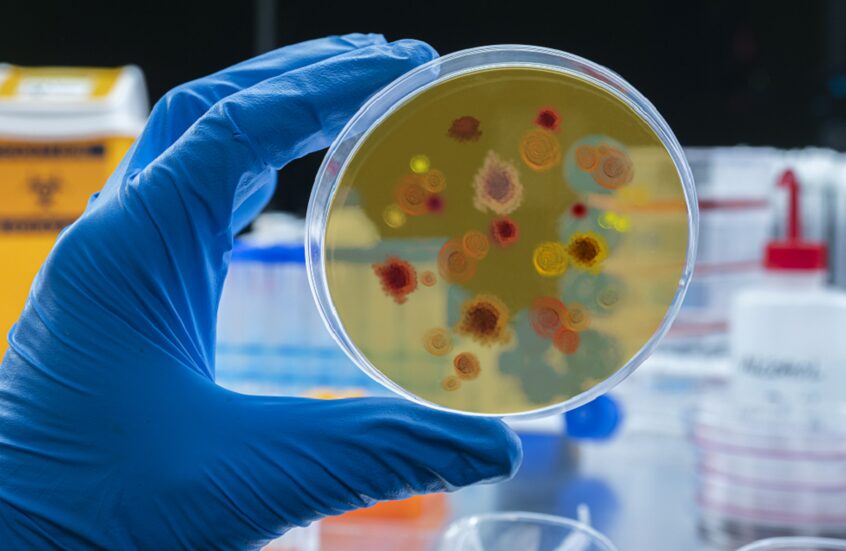

أقرت منظمة الصحة العالمية اعتماد أول علاج دوائي في العالم مخصص خصيصًا للملاريا لدى الرضع، في خطوة توصف بأنها تحول طبي مهم في مواجهة أحد أكثر الأمراض فتكًا بالأطفال في المناطق الموبوءة، وعلى رأسها القارة الإفريقية.
وأعلنت المنظمة، قبيل اليوم العالمي للملاريا الذي يوافق 25 أبريل، اعتماد تركيبة دوائية تحمل اسم أرتيميثير-لوميفانترين، صُممت خصيصًا لتناسب حديثي الولادة والرضع الذين يصل وزنهم إلى 5 كيلوغرامات، لتكون أول صيغة علاجية موجهة لهذه الفئة العمرية الدقيقة.
ويأتي هذا القرار في ظل فجوة علاجية ممتدة، إذ تشير التقديرات إلى أن نحو 30 مليون رضيع يولدون سنويًا في مناطق ينتشر فيها مرض الملاريا، خصوصًا في إفريقيا، حيث ظل العديد منهم يتلقى جرعات مخصصة للأطفال الأكبر سنًا، وهو ما كان يرفع احتمالات التعرض لآثار جانبية غير مناسبة لحديثي الولادة.
وتؤكد بيانات منظمة الصحة العالمية أن الأطفال دون سن الخامسة يشكلون نحو 75 في المئة من إجمالي الوفيات المرتبطة بالملاريا، ما يعكس حجم التهديد الذي يواجه هذه الفئة العمرية رغم توافر وسائل الوقاية والعلاج.
وفي إطار الوقاية، توصي المنظمة باستخدام الناموسيات المعالجة بالمبيدات للرضع والبالغين على حد سواء، باعتبارها خط الدفاع الأول للحد من التعرض للدغات البعوض الناقل للمرض منذ المراحل المبكرة من الحياة.
وفي موازاة هذا التطور العلاجي، كشف فريق بحثي دولي من كندا والولايات المتحدة وهولندا عن لقاح جديد ضد الملاريا أظهر نتائج واعدة في التجارب ما قبل السريرية، بعد استخدام تقنيات علمية متقدمة لتحليل بنية الطفيلي المسبب للمرض وتحديد الأجزاء الأكثر قدرة على تحفيز المناعة.
وأوضح الباحث في مستشفى الأطفال المرضى في تورنتو، دانتون إيفانوشكو، أن الهدف من هذا التطوير هو الوصول إلى لقاح أكثر فعالية من المتوفر حاليًا، مشيرًا إلى أن دمج أجزاء رئيسية من الطفيلي أدى إلى استجابة مناعية أقوى مقارنة باللقاحات التقليدية.
كما استخدم الفريق البحثي تقنيات متقدمة لرسم خريطة الأجسام المضادة البشرية المرتبطة باللقاح، ما عزز الثقة في فعاليته على المستوى الجزيئي وساعد في تقليل الشكوك قبل الانتقال إلى التجارب السريرية.
ومن المتوقع أن يخضع اللقاح لمزيد من الاختبارات، مع احتمالية انتقاله إلى التجارب السريرية خلال السنوات المقبلة، في حال استمرار النتائج الإيجابية.
ويعكس هذا التزامن بين اعتماد علاج مخصص للرضع وتطور لقاح جديد ضد الملاريا مرحلة علمية متقدمة في مواجهة المرض، مع آمال متزايدة في خفض الإصابات والوفيات، خصوصًا بين الأطفال الذين يمثلون الفئة الأكثر عرضة للخطر عالميًا.
هذا وتعد الملاريا من أخطر الأمراض الطفيلية المنتشرة في المناطق المدارية، وتنتقل عبر لدغات بعوض الأنوفيلس. وعلى الرغم من التقدم الطبي، لا تزال إفريقيا تتحمل النسبة الأكبر من الإصابات والوفيات عالميًا، خصوصًا بين الأطفال دون سن الخامسة، ما يجعل تطوير علاجات ولقاحات مخصصة لهم خطوة محورية في الصحة العالمية.